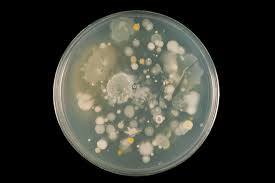
Launch of world’s first Crop Microbiome CryoBank

How to get quality and quantity year after year
What were your results like this year? Could you do better? Getting higher quality and quantity from the crop with more strategic use of inputs is one of the benefits of precision farming and a number of the most promising developments in this area are going to be presented at our next event, co-hosted by Niab: ‘Innovations for Sustainable Intensification’.
We asked Stuart Knight, Deputy Director of Niab, about the progress that is being made by the SIP (Sustainable Intensification Platform) Project 1, a research programme funded by Defra and the Welsh Government.
He explains that the aim of SIP is to provide practical advice for farmers by bringing together a multi-disciplinary community spanning academia, industry, environment and policy to look at the issues from many angles.
Alternative cultivation
We have been evaluating a range of farm management practices which could be adopted more widely. For arable, this includes over-winter cover crops, less intensive cultivation systems and using organic wastes as fertilisers. For livestock we have been evaluating reseeding of permanent pasture with high sugar grasses, improving grassland soils and grazing systems.
Improving soil fertility through selection of the most appropriate cultivation technique is a good example of how yields can be improved, environment impacts reduced and resilience to climate change increased. We are looking for these win-win scenarios and capturing the knowledge effectively.
The project has developed new approaches to measuring the environmental as well as the economic performance of farms, without requiring large amounts of new data to be collected. Work on the different study farms is ongoing, and has already demonstrated the potential for changed farming practices to help deliver SI. The results should provide growers and advisers with additional information and tools to help meet the challenges and make the most of the opportunities of sustainable intensification.
Farm profitability
Sustainable intensification is all about trying to improve farm profitability and environmental performance at the same time. Efficiency is key to both current profitability and minimising emissions to air or losses to water. Enhancing the soil and biodiversity are important environmental objectives but can also contribute to improvements in future productivity and resilience.
Stuart will be talking at ‘Innovations for Sustainable Intensification’; find out more here.
Agri-TechE